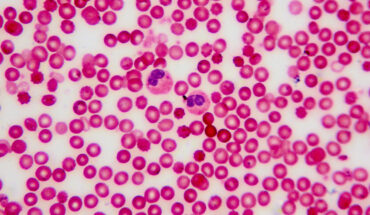

Health and medical Category


Quibim Launches AI-Powered Prostate MRI Imaging Quality Assessment

Mölnlycke Health Care makes record investment

TikTok food sellers may be risking people’s health

Child safety week in Warwickshire

Novel PCOS App with Hair Loss Tracker

Is hardwater good for you?

Is the air we share a toxic soup of invisible pollutants?

University wins national award for drug overdose training partnership
Improving blood culture diagnostics across the NHS

Peroxide injections may boost radiotherapy treatment
